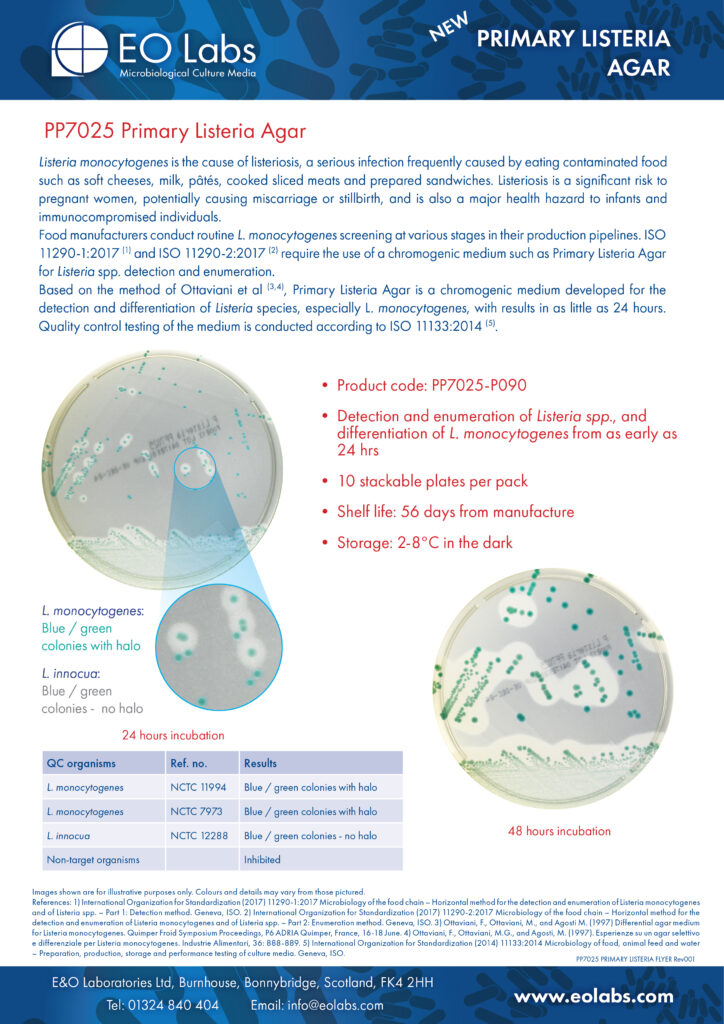

Product Flyers
Creation of product flyers is part of my remit. Given the nature of the products manufactured at my current employer and the complexities of their use, flyers tend to contain a lot of information important to the end-user scientists who will use the products: product images, primary packaging, shipping packaging, the types of organisms the product is intended to be used with – that kind of thing.
A selection of the flyers I’ve developed are below. All imagery used in the flyers was shot and edited by me with copy borrowed from Instruction for Use documentation, or written by me.